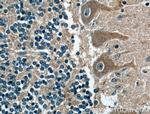
CNTF Antibody in Immunohistochemistry (Paraffin) (IHC (P))

Search
Proteintech
CNTF Polyclonal Antibody
{{$productOrderCtrl.translations['antibody.pdp.commerceCard.promotion.promotions']}}
{{$productOrderCtrl.translations['antibody.pdp.commerceCard.promotion.viewpromo']}}
{{$productOrderCtrl.translations['antibody.pdp.commerceCard.promotion.promocode']}}: {{promo.promoCode}} {{promo.promoTitle}} {{promo.promoDescription}}. {{$productOrderCtrl.translations['antibody.pdp.commerceCard.promotion.learnmore']}}
产品信息
27342-1-AP
种属反应
宿主/亚型
分类
类型
抗原
偶联物
形式
浓度
规格
纯化类型
保存液
内含物
保存条件
运输条件
产品详细信息
Immunogen sequence: MAFTEHSPL TPHRRDLCSR SIWLARKIRS DLTALTESYV KHQGLNKNIN LDSADGMPVA STDQWSELTE AERLQENLQA Y (1-80 aa encoded by BC074964)
靶标信息
The protein encoded by this gene is a polypeptide hormone whose actions appear to be restricted to the nervous system where it promotes neurotransmitter synthesis and neurite outgrowth in certain neuronal populations. The protein is a potent survival factor for neurons and oligodendrocytes and may be relevant in reducing tissue destruction during inflammatory attacks. A mutation in this gene, which results in aberrant splicing, leads to ciliary neurotrophic factor deficiency, but this phenotype is not causally related to neurologic disease. A read-through transcript variant composed of ZFP91 and CNTF sequence has been identified, but it is thought to be non-coding. Read-through transcription of ZFP91 and CNTF has also been observed in mouse.
仅用于科研。不用于诊断过程。未经明确授权不得转售。
生物信息学
蛋白别名: Ciliary Neuronotrophic Factor; Ciliary neurotrophic factor; CNTF; H-CNTF; unnamed protein product
基因别名: CNTF; HCNTF
UniProt ID: (Human) P26441
Entrez Gene ID: (Human) 1270